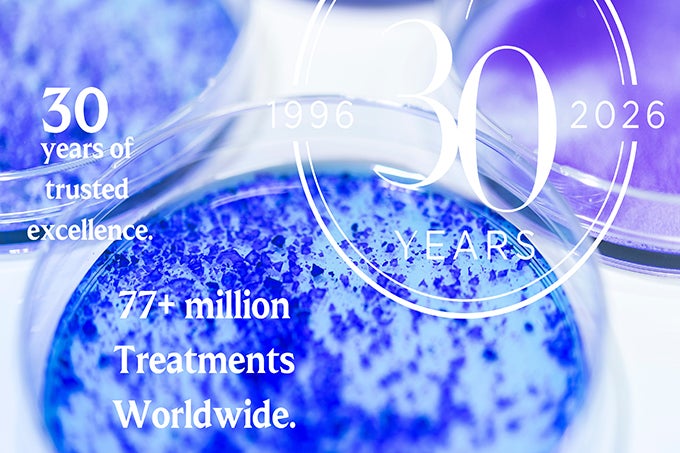
レスチレン30周年キャンペーン

ガルデルマ製 ヒアルロン酸注入材が30周年キャンペーンスタート
April 7, 2026
― 科学に裏づけられた“自然な美しさ” ―
1996年、世界初の非動物由来の安定化ヒアルロン酸注入材としてヨーロッパで誕生してから30年。
ガルデルマ製ヒアルロン酸注入材は、世界の美容医療とともに歩んできました。
累計7,700万回以上に及ぶ施術実績は、世界初のFDA承認を取得したガルデルマ製のヒアルロン酸注入材が、医療現場と患者様の双方から選ばれ続けてきた「信頼の積み重ね」です。また、昨年は、日本において10年ぶりとなる新製品の発売が開始されました。
アニバーサリーイヤーの幕開けとなる4月より、感謝の気持ちを込めて、医療従事者の皆様へ向けた新たなコンテンツやキャンペーンを順次展開いたします。
日本の先生方のさらなる治療の可能性を広げる一助となれば幸いです。
私たちは、科学的根拠に基づく製品開発を通じ、外見の美しさだけでなく内面の健やかさも支えることを目指しています。
一人ひとりの豊かな人生に寄り添い、皮膚科学の未来を皆様とともに創造してまいります。